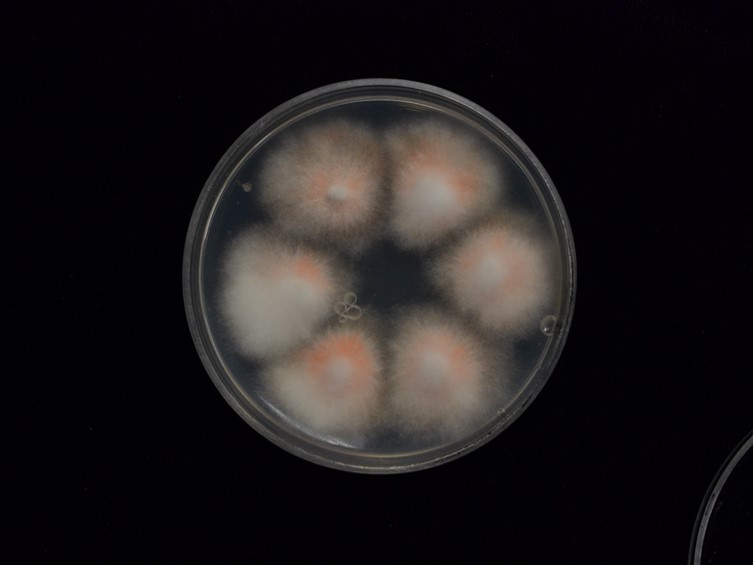

Holotype:
THAILAND, Chiang Mai Province, Ban Hua Thung Community Forest, 26 Oct. 2013, K. Tasanathai, P. Srikitikulchai, A. Khonsanit, W. Noisripoom, D. Thanakitpipattana, S. Watcharapayungkit, holotype BBH 37807, ex-type living culture BCC 68459.
Habitat:
Buried in soil, leaf litter.
Host:
Coleopteran larva.
Description:
 Stromata simple or compound, solitary to gregarious, cylindrical to clavate, almost translucent white, or light pink to pale salmon, slightly flexuose, arising from the head or abdomen of host. Rhizoids flexuous, extending from the host ca 1-2 cm under the ground. Terminal part of the stroma fertile, light yellow to pale orange, 2-7 × 1-1.5 mm.
Stromata simple or compound, solitary to gregarious, cylindrical to clavate, almost translucent white, or light pink to pale salmon, slightly flexuose, arising from the head or abdomen of host. Rhizoids flexuous, extending from the host ca 1-2 cm under the ground. Terminal part of the stroma fertile, light yellow to pale orange, 2-7 × 1-1.5 mm.  Perithecia superficial, narrowly ovoid to obclavate, 200-450 × 70-170 μm, clustered halfway to the apex.
Perithecia superficial, narrowly ovoid to obclavate, 200-450 × 70-170 μm, clustered halfway to the apex.  Asci cylindrical, 8-spored, 175-315 × 2-3 μm, bottom and apex thicker than the middle part. Ascospores smooth, whole, bola-shaped, 200- 300 μm in length, central part filiform, terminal parts narrowly fusiform, with four cells 25-30 × 1 μm, with three septa.
Asci cylindrical, 8-spored, 175-315 × 2-3 μm, bottom and apex thicker than the middle part. Ascospores smooth, whole, bola-shaped, 200- 300 μm in length, central part filiform, terminal parts narrowly fusiform, with four cells 25-30 × 1 μm, with three septa.
Culture characteristics:
Colonies on PDA are relatively fast-growing, attaining a diam. of 10 mm in 7 d at 22 °C, at the first white, cottony, becoming pale orange to red orange with age. Reverse light orange. Evlachovaea-like and mariannaea-like conidial morphs developing after 1 week. Conidia ovoid, elongating to be cylindrical with age, hyaline, smooth-walled, 4–10 × 1.5–2 μm. Phialides hyaline, cylindrical with tapering ends, smooth-walled, 5–22.5 × 1–2 μm.
Colonies on PDA are relatively fast-growing, attaining a diam. of 10 mm in 7 d at 22 °C, at the first white, cottony, becoming pale orange to red orange with age. Reverse light orange. Evlachovaea-like and mariannaea-like conidial morphs developing after 1 week. Conidia ovoid, elongating to be cylindrical with age, hyaline, smooth-walled, 4–10 × 1.5–2 μm. Phialides hyaline, cylindrical with tapering ends, smooth-walled, 5–22.5 × 1–2 μm.
Reference:
Tasanathai K, Thanakitpipattana D, Noisripoom W, et al. (2016). Two new Cordyceps species from a community forest in Thailand. Mycological Progress 15: 28.
DOI: http://doi.org/10.1007/s11557-016-1170-3Species |
Strain |
Compound |
Pubchem CID |
Biological activity |
Reference |
|---|
|
Strain |
ITS | TEF1 |
|---|---|---|
| BCC 68469 | KT261393 | KT261403 |
| BCC 75733 | KT261397 | KT261407 |
| BCC 75734 | KT261394 | KT261404 |
| BCC 75755 | KT261395 | KT261405 |
| BCC 75756 | KT261396 | KT261406 |